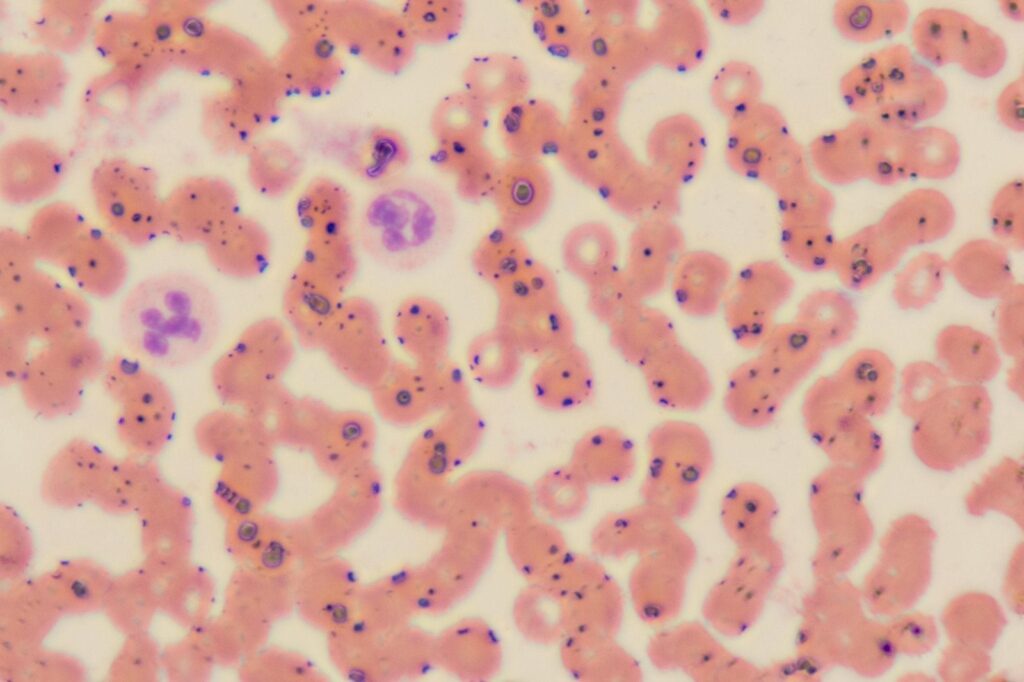

The Science Behind Quick Fix Synthetic Urine and Its Applications in Modern Labs
Synthetic urine rarely gets serious scientific attention in mainstream coverage. Most articles treat it as a novelty or a controversy. That framing misses the actual story, the chemistry, the engineering, and the legitimate laboratory applications that drive demand for products like Quick Fix among researchers, device manufacturers, and clinical quality assurance professionals. This article looks […]
The Science Behind Quick Fix Synthetic Urine and Its Applications in Modern Labs Read More »